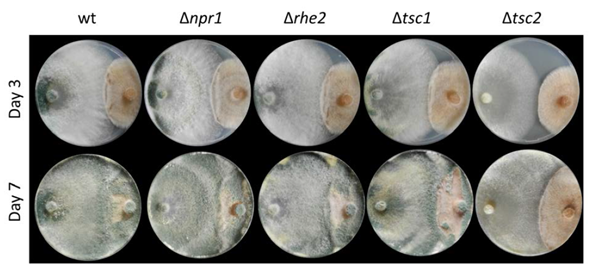
cultures

Projekte
Tricho-TOR

PI: Susanne Zeilinger

Mycoparasitic fungi antagonize other fungi by overgrowing and parasitizing their fungal preys. Trichoderma atroviride is a potent mycoparasite applied as sustainable alternative to synthetic fungicides in the protection of plants against fungal phytopathogens. Its mycoparasitic activity involves processes shared with plant and human pathogenic fungi such as the production of cell wall degrading enzymes and secondary metabolites and is tightly regulated by environmental cues including nutrients and prey fungus-derived signals.
We study the TOR (Target Of Rapamycin) kinase pathway, which is known from studies in yeast and mammalian cells to regulate growth in response to nutrient availability, as an essential signalling hub in Trichoderma atroviride. T. atroviride possesses a single TOR kinase, which we named Tor1. Alteration of Tor1 activity by treatment with chemical inhibitors or by genetic manipulation of selected TOR pathway components revealed Tor1 signaling as a key player in regulating growth and metabolism as well as mycoparasitism-relevant functions. Our results provide the first in-depth insights into the role of this important regulatory pathway in a mycoparasitic fungus which is of utmost importance for the enhancement and targeted application of Trichoderma atroviride as a biocontrol agent.
Confrontation assays for assessing the mycoparasitic activity of Δnpr1, Δrhe2, Δtsc1 and Δtsc2 mutants (left side) against R. solani (right side).
Relevant publications:
